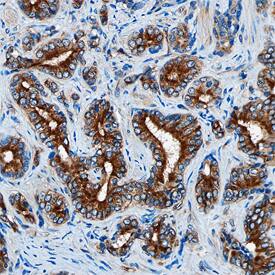
DAB2 antibody in Human Prostate by Immunohistochemistry (IHC-P).

Human DAB2 Antibody
R&D Systems, part of Bio-Techne | Catalog # MAB8064


Key Product Details
Species Reactivity
Applications
Label
Antibody Source
Product Specifications
Immunogen
Lys630-Ala770
Accession # P98082
Specificity
Clonality
Host
Isotype
Scientific Data Images for Human DAB2 Antibody
Detection of Human DAB2 by Western Blot.
Western blot shows lysates of A172 human glioblastoma cell line and HeLa human cervical epithelial carcinoma cell line. PVDF membrane was probed with 1 µg/mL of Mouse Anti-Human DAB2 Monoclonal Antibody (Catalog # MAB8064) followed by HRP-conjugated Anti-Mouse IgG Secondary Antibody (Catalog # HAF018). A specific band was detected for DAB2 at approximately 100 kDa (as indicated). This experiment was conducted under reducing conditions and using Immunoblot Buffer Group 1.DAB2 in HeLa Human Cell Line.
DAB2 was detected in immersion fixed HeLa human cervical epithelial carcinoma cell line using Mouse Anti-Human DAB2 Monoclonal Antibody (Catalog # MAB8064) at 10 µg/mL for 3 hours at room temperature. Cells were stained using the NorthernLights™ 557-conjugated Anti-Mouse IgG Secondary Antibody (red; Catalog # NL007) and counterstained with DAPI (blue). Specific staining was localized to cytoplasm. View our protocol for Fluorescent ICC Staining of Cells on Coverslips.DAB2 in Human Prostate.
DAB2 was detected in immersion fixed paraffin-embedded sections of human prostate using Mouse Anti-Human DAB2 Monoclonal Antibody (Catalog # MAB8064) at 15 µg/mL overnight at 4 °C. Tissue was stained using the Anti-Mouse HRP-DAB Cell & Tissue Staining Kit (brown; Catalog # CTS002) and counterstained with hematoxylin (blue). Specific staining was localized to the cytoplasm of epithelial cells. View our protocol for Chromogenic IHC Staining of Paraffin-embedded Tissue Sections.Applications for Human DAB2 Antibody
Immunocytochemistry
Sample: Immersion fixed HeLa human cervical epithelial carcinoma cell line
Immunohistochemistry
Sample: Immersion fixed paraffin-embedded sections of human prostate
Western Blot
Sample: A172 human glioblastoma cell line and HeLa human cervical epithelial carcinoma cell line
Reviewed Applications
Read 1 review rated 5 using MAB8064 in the following applications:
Formulation, Preparation, and Storage
Purification
Reconstitution
Formulation
Shipping
Stability & Storage
- 12 months from date of receipt, -20 to -70 °C as supplied.
- 1 month, 2 to 8 °C under sterile conditions after reconstitution.
- 6 months, -20 to -70 °C under sterile conditions after reconstitution.
Background: DAB2
DAB2 (Drosophila disabled homolog 2; also DOC-2/Differentially-expressed in Ovarian Carcinoma and p96) is a cytoplasmic phosphoprotein. Although the predicted MW is 82 kDa, it runs anomalously at 95-105 kDa in SDS-PAGE. It is widely expressed, being found in ovarian cuboidal epithelium, megakaryocytes, fibroblasts, macrophages, breast epithelium and renal proximal tubule cells. Reduced expression levels are associated with tumor development. DAB2 has multiple functions, but is typically described as an adaptor protein (i.e.-one that supports the apposition of two interacting molecules) involved in intracellular trafficking. Molecules reported to interact with DAB2 include megalin, SMAD2 plus TGF-beta RI/II, axin and Dvl3. With respect to trafficking, DAB2 reportedly binds to AP-2, clathrin, LRP6 and myosin VI, four molecules associated with the endocytic process. Human DAB2 is 770 amino acids (aa) in length. It contains one pleckstrin homology-like domain that binds phosphotyrosine (aa 42-170) and a C-terminal Pro-rich region that binds SH3 domains (aa 600-630). There are two isoform variants. One is 80-82 kDa in size and shows a deletion of aa 230-447. The second exhibits a short deletion of aa 209-229. Over aa 630-770, human DAB2 shares 76% aa sequence identity with mouse DAB2.
Long Name
Alternate Names
Gene Symbol
UniProt
Additional DAB2 Products
Product Documents for Human DAB2 Antibody
Product Specific Notices for Human DAB2 Antibody
For research use only